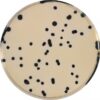

Urea GR for analysis ACS,Reag. Ph Eur
0 ₫
Carbamide, Carbonyl diamide, Diaminomethanone, Carbonyldiamine, CO(NH₂)₂ Độ tinh khiết 99.0 – 100 %, Urea GR để phân tích ACS sử dụng trong phòng thí nghiệm, công nghiệp, sản xuất…
|
Công thức hóa học |
CO(NH₂)₂ |
|
Khối lượng mol |
60,06 g / mol |
|
Trạng thái |
Rắn |
|
Khối lượng riêng |
1,34 g / cm3 (20 ° C) |
|
Nhiệt độ nóng chảy |
133 ° C |
|
pH |
9 (100 g / l, H₂O, 20 ° C) |
|
Mật độ |
720 – 760 kg / m3 |
|
Độ hòa tan |
1000 g / l |
|
Quy cách đóng gói |
Chai nhựa 500g |
|
Bảo quản |
+ 15 ° C đến + 30 ° C. |
|
Một số thành phần |
Độ tinh khiết : 99 – 100.5% NH₄ (Ammonium)≤ 0.0500 % Chloride (Cl) ≤ 0.0005 % Sulfate (SO₄) ≤ 0.001 % Heavy metals (as Pb) ≤ 0.0004 % Cu (Copper)≤ 0.0001 % Pb (Lead) ≤ 0.0002 % |
|
Ứng dụng |
Nguyên liệu cho sản xuất chất dẻo, đặc biệt là nhựa urê-formalđêhít.
|
Hãy là người đầu tiên nhận xét “Urea GR for analysis ACS,Reag. Ph Eur” Hủy
Sản phẩm tương tự
Hóa chất thí nghiệm
Hóa chất thí nghiệm
CAL Check™ chuẩn Clo thang cao, 0.00 và 4.00 mg/L HI96734-11 Hanna
Hóa chất thí nghiệm
Hóa chất thí nghiệm
Cal Check chuẩn Clo dư và Clo tổng, 0.00 và 1.00 mg/l HI93414-11 Hanna
Hóa chất thí nghiệm
Hóa chất thí nghiệm
CAL Check™ Chuẩn Mangan Thang Thấp, 0 và 150 μg/L HI96748-11 Hanna
Hóa chất thí nghiệm
CAL Check™ Chuẩn Amoni Thang Cao, 0.0 và 25.0 mg/L HI96733-11 Hanna
Hóa chất thí nghiệm

Đánh giá
Chưa có đánh giá nào.